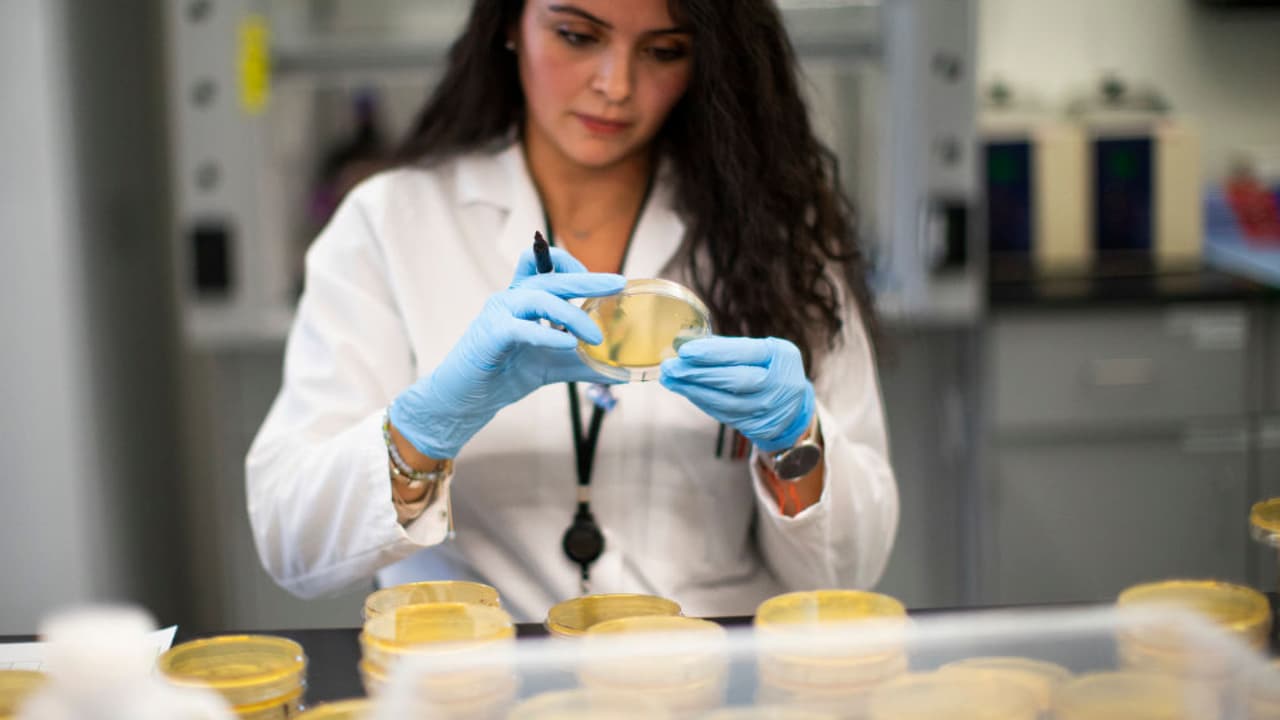

Con el comienzo de año y la aprobación de vacunas contra el covid-19, hay quienes creen que lo peor de la pandemia ha quedado atrás y que la normalidad está a la vuelta de la esquina. La realidad es otra: aunque es cierto que ahora la humanidad cuenta con una poderosa arma para vencer el nuevo coronavirus (las vacunas), aún queda un largo trecho por recorrer, uno que – se teme- sea posiblemente el más oscuro.
El mensaje que no quieres (pero debes) escuchar a comienzos del 2021: la pandemia va a empeorar
Si bien hay razones para la esperanza, es demasiado temprano para aferrarse ciegamente a ella y relajarse. La aprobación de las vacunas es solo un factor en una compleja ecuación donde todavía quedan obstáculos por sortear. Entre ellos: la amenaza de una cepa aún más contagiosa. Para reajustar las expectativas, lee a continuación.

No por casualidad el Reino Unido acaba de decretar un confinamiento nacional ante la amenaza de una nueva variante más contagiosa.
“ No es lo que nadie quiere escuchar, pero los próximos meses bien pueden ser los más duros de esta pandemia. Si pensabas que las vacunas serían la luz al final del túnel, sí: esa luz está ahí y es igual de brillante, pero el túnel simplemente se tornó más oscuro y largo”, escribió el biólogo molecular y corresponsal de Science Magazine, Kai Kupferschmidt en un hilo de Twitter.
Amanecerá, sí, pero más tarde de lo que muchos anticipan y este es el peor de los momentos para bajar la guardia y seguir adelante con nuestras vidas como si el virus no estuviera al acecho. La evasión, aunque tentadora, sólo prolongará la agonía -advierten los expertos-.
It’s not what anyone wants to hear, but the coming months may well be the hardest of this pandemic. If you’ve been thinking of vaccines as the light at the end of the tunnel: Yes, that light is there, as bright as ever. But the tunnel just got a bit darker and a little bit longer
— Kai Kupferschmidt (@kakape) January 2, 2021
“ Este no es el momento para dejar de ser cautelosos. Estamos en el peor momento de la pandemia. Estamos viendo cifras récord de contagios, hospitalizaciones y muertes en muchas partes del país y, aunque las vacunas ofrecen esperanza, llegarán demasiado tarde para salvar a muchas personas. Tenemos que redoblar las precauciones”, insiste en conversación con Univision Noticias, Leana Wen, médico de emergencia y profesora de Salud Pública de la Universidad de George Washington, quien en el pasado sirvió como Comisionada de Salud de la ciudad de Baltimore.
En efecto, para el 3 de enero se reportaron en Estados Unidos más de 1,353 nuevas muertes y 201,980 nuevos casos, para un total de más de 20 millones de contagios y 350,000 fatalidades por covid-19 en el país según el New York Times. Y, lo peor, esas cifras aun no reflejan lo que ocurrió durante las festividades decembrinas cuyo impacto se sabrá en las próximas semanas.
“Habrá mucho dolor en el primer cuarto del 2021”, dijo a The Atlantic, Anthony Fauci, director del Instituto Nacional de Alergias y Enfermedades Infecciosas.
En este punto de la pandemia, tras meses de restricciones, es doloroso admitirlo, pero quedan obstáculos por sortear. Reconocerlos es el primer paso para superarlos. No se trata de perder la esperanza o de resignarse, pero sí de reajustar las expectativas.